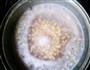
玉米紫薯汁的做法图解4

| 玉米紫薯汁热量分析 (可根据实际输入食材份量计算。数据仅供参考) | |||||
|---|---|---|---|---|---|
| 食材名称 | 食材份量 | 热量 | 标准度量(每100克) | 蛋白质 | 脂肪 |
| 玉米 | 克 | 280千卡 | 196千卡 | 4克 | 1克 |
| 紫薯 | 克 | 164千卡 | 74千卡 | 2.34克 | 0克 |
| 总量 | 365克 | 玉米紫薯汁热量/卡路里444千卡 | |||

1/7. 已经蒸熟的紫薯一个。然后切小块。备用。当然可以和玉米一起煮,我正好有熟的就直接拿来用了。

2/7. 玉米掰下玉米粒。

3/7. 掰好的玉米粒
4/7. 里放水,煮熟。

5/7. 豆浆机里倒入煮熟的玉米粒和水,加入紫薯。启动果汁功能,打好。

6/7. 玉米粒的皮会影响口感。需要过滤

7/7. 好喝。天然好味道。
玉米的热量196千卡(每100克);有利含量:低胆固醇,低钠盐,低饱和脂肪酸,富含磷,富含钾;具有利水通淋、促进胃肠蠕动、降低胆固醇等功效;可与草莓、橙子、酸奶搭配;与海螺、扇贝、红薯相克,同食可能会引起不适;
紫薯的热量74千卡(每100克);有利含量:低胆固醇,低钠盐,低饱和脂肪酸;具有提高免疫力、减肥、益气力等功效;可与排骨、芹菜、猪排搭配;与燕麦、螃蟹、鸡翅相克,同食可能会引起不适;